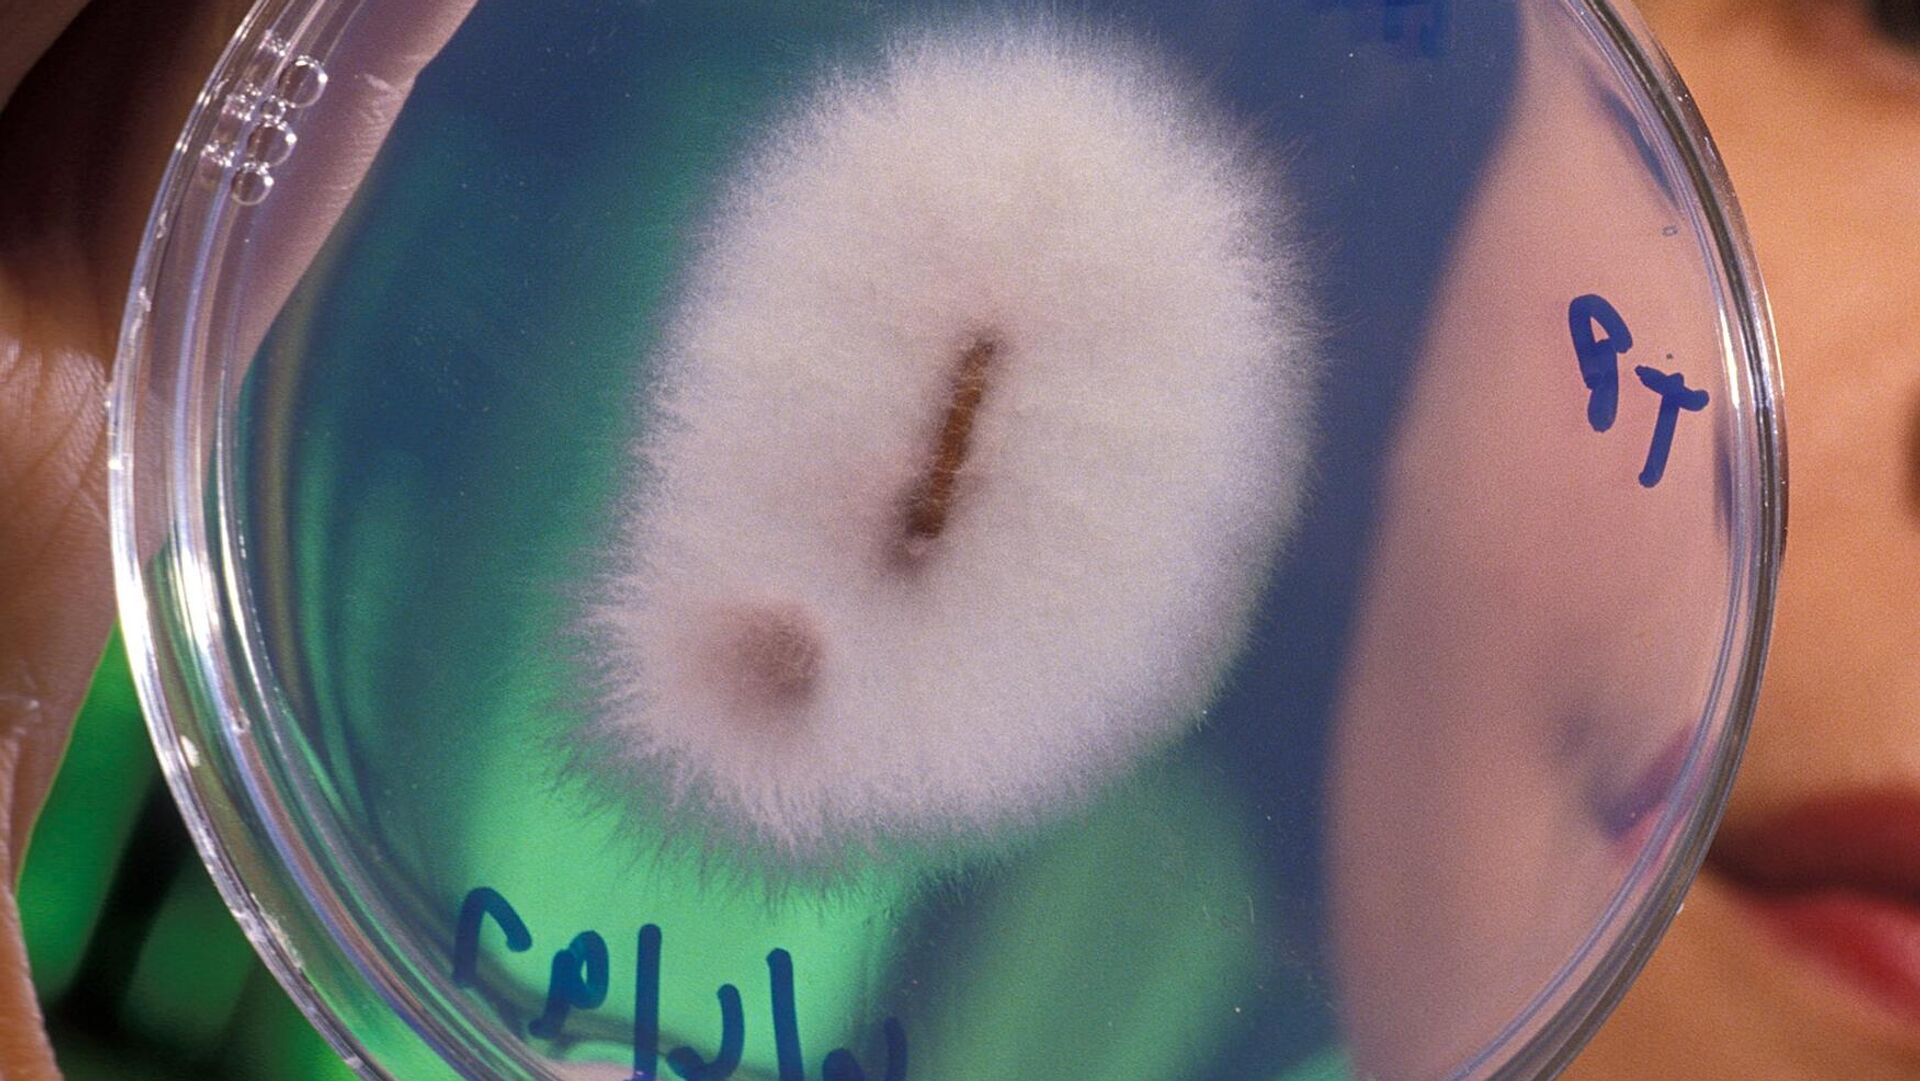

https://noticiaslatam.lat/20210429/1111748036.html
Ecuador duerme con un ojo abierto ante el mortal hongo del banano
Ecuador duerme con un ojo abierto ante el mortal hongo del banano
Sputnik Mundo
QUITO (Sputnik) — El hongo Fusarium oxysporum, que causa en las plantaciones bananeras la enfermedad Fusarium Raza 4 Tropical (TR4), mantiene a los productores... 29.04.2021, Sputnik Mundo
2021-04-29T22:13+0000
2021-04-29T22:13+0000
2021-04-30T00:41+0000
américa latina
💬 opinión y análisis
ecuador
hongos
📈 mercados y finanzas
https://cdn.img.noticiaslatam.lat/img/07e5/04/1d/1111748003_0:371:1752:1357_1920x0_80_0_0_f0ebfc5d65b53acb90690d8ae37e6643.jpg
Ecuador es uno de los mayores productores y el principal exportador de banano en el mundo. El fruto es mayormente apetecido en grandes mercados de Rusia, Europa, y Estados Unidos, entre otros.El agresivo hongo apareció en la década de los 90 en Taiwán, y en 12 años afectó unas 1.200 hectáreas para luego extenderse a los países del sudeste asiático y África y, finalmente, llegar a Latinoamérica.Expertos dicen que los efectos del hongo son tan letales como la fiebre aftosa en los bovinos, la influenza aviar H5N1 en las aves, la peste porcina en los cerdos o la viruela en los humanos.José Antonio Hidalgo, presidente de la Asociación de Exportadores de Banano del Ecuador (AEBE), asegura a Sputnik que el hongo no ha entrado al país, pero subrayó la necesidad de medidas preventivas.Prevención tempranaDesde 2018, Ecuador refuerza planes, protocolos y normativas, y al momento existen al menos 11 resoluciones técnicas y acuerdos ministeriales que, desde el punto de vista normativo, a través de análisis de riesgo, tratan de impedir el ingreso del hongo por las diversas vías.El director ejecutivo de la Agencia de Regulación y Control Fito y Zoosanitario (Agrocalidad), Patricio Almeida, cuenta a esta agencia que en prevención del ingreso del hongo Ecuador suspendió desde 2014 la importación de todo material de siembra.Las medidas se actualizan constantemente: al momento, todos los contenedores que ingresan por los puertos ecuatorianos son desinfectados; se desinfecta maquinaria que pueda ser utilizada en construcción, en vialidad u otros; igualmente, vehículos y personas que ingresan por la frontera norte y por frontera sur cumplen un procedimiento estricto de desinfección.En los pasos peatonales de frontera están instalados arcos de desinfección; se utilizan bombas estacionarias para desinfectar vehículos, y pediluvios para la desinfección de calzado, con lo que se busca evitar el posible ingreso de esporas del hongo.Plan actualizadoEn 2020, Ecuador actualizó el Plan de Contingencia para fortalecer las medidas de cuarentena y de bioseguridad de cada finca bananera. Este incluye establecer los puntos críticos de ingreso y capacitar a los productores para que implementen acciones como desinfección del calzado, machetes y otras herramientas de trabajo.Desde 2019, Agrocalidad y el Ministerio de Agricultura mantienen campañas de capacitación para los cerca de 15.000 productores bananeros.Entre 2019 y 2020 se capacitó a cerca de 20.000 actores de la cadena productiva, con especial énfasis en pequeños productores, que constituyen el 80% de cultivadores de la fruta.40.000 monitoreosLa vigilancia, desde 2018, se hace a través de una modelación de mapas de riesgo para determinar cuáles son los puntos críticos en los que hay que enfocar los esfuerzos para detectar posibles plantas con síntomas y, si las hay, tomar muestras y enviarlas al laboratorio.Desde 2018 el equipo ha hecho cerca de 40.000 monitoreos en todas las zonas bananeras del país.Cuando el hongo llegó a Colombia, en 2019, se incrementaron las inspecciones en frontera, los controles en pasajeros y el contacto con los productores para que se implementen las medidas de bioseguridad.Entra limpio y sal limpioEntre los productores se ha impartido el concepto "entra limpio, sal limpio", con el que se exhorta a los trabajadores a la desinfección tanto al ingreso como a la salida de la finca para evitar que se disemine cualquier tipo de problema fitosanitario a otras áreas.Agrocalidad también ha conformado el denominado Comando Raza 4, conformado por técnicos que han sido entrenados por entes como el Organismo Internacional Regional de Sanidad Agropecuaria de Centroamérica (OIRSA) para que adopten tanto las medidas preventivas como las emergentes ante una alerta, un supuesto brote o un brote.Los integrantes del Comando están en toda la zona bananera, pero han redoblado esfuerzos en la zona sur, desde que se confirmó el brote en Perú, más cercano a la zona bananera de Ecuador.
https://noticiaslatam.lat/20210426/1111601494.html
https://noticiaslatam.lat/20210311/estos-hongos-imitan-a-las-flores-y-enganan-a-los-insectos-como-lo-hacen--1109850743.html
https://noticiaslatam.lat/20210224/la-pandemia-del-banano-avanza-y-america-latina-se-suma-a-la-alerta-mundial-1109164476.html
https://noticiaslatam.lat/20190814/que-se-sabe-de-la-plaga-que-ha-puesto-a-colombia-en-emergencia-nacional-1088379233.html
https://noticiaslatam.lat/20171031/plaga-platanera-contaminacion-1073604291.html
ecuador
Sputnik Mundo
contacto@sputniknews.com
+74956456601
MIA „Rossiya Segodnya“
2021
Noticias
es_ES
Sputnik Mundo
contacto@sputniknews.com
+74956456601
MIA „Rossiya Segodnya“
Sputnik Mundo
contacto@sputniknews.com
+74956456601
MIA „Rossiya Segodnya“
💬 opinión y análisis, ecuador, hongos, 📈 mercados y finanzas
💬 opinión y análisis, ecuador, hongos, 📈 mercados y finanzas
Ecuador duerme con un ojo abierto ante el mortal hongo del banano
22:13 GMT 29.04.2021 (actualizado: 00:41 GMT 30.04.2021) QUITO (Sputnik) — El hongo Fusarium oxysporum, que causa en las plantaciones bananeras la enfermedad Fusarium Raza 4 Tropical (TR4), mantiene a los productores ecuatorianos en vilo, pues aunque todavía no ha entrado al país ya afecta a sus vecinos Colombia y Perú.
Ecuador es uno de los mayores productores y el principal exportador de banano en el mundo. El fruto es mayormente apetecido en grandes mercados de Rusia, Europa, y Estados Unidos, entre otros.
El agresivo hongo apareció en la década de los 90 en Taiwán, y en 12 años afectó unas 1.200 hectáreas para luego extenderse a los países del sudeste asiático y África y, finalmente, llegar a Latinoamérica.

26 de abril 2021, 21:50 GMT
Expertos dicen que los efectos del hongo son tan letales como la fiebre aftosa en los bovinos, la influenza aviar H5N1 en las aves, la peste porcina en los cerdos o la viruela en los humanos.
José Antonio Hidalgo, presidente de la Asociación de Exportadores de Banano del Ecuador (AEBE), asegura a Sputnik que el hongo no ha entrado al país, pero subrayó la necesidad de medidas preventivas.
"Las claves son prevención disciplina, capacitación y financiamiento. Este es un esfuerzo de todos, incluidos productores", destaca Hidalgo.
Desde 2018, Ecuador refuerza planes, protocolos y normativas, y al momento existen al menos 11 resoluciones técnicas y acuerdos ministeriales que, desde el punto de vista normativo, a través de análisis de riesgo, tratan de impedir el ingreso del hongo por las diversas vías.
El director ejecutivo de la Agencia de Regulación y Control Fito y Zoosanitario (Agrocalidad), Patricio Almeida, cuenta a esta agencia que en prevención del ingreso del hongo Ecuador suspendió desde 2014 la importación de todo material de siembra.
"Los países que producimos banano siempre estamos viendo mejora genética en el material de siembra, y hay países que investigan y desarrollan muchísimo estos materiales, por ejemplo en Medio Oriente, en Asia; la primera medida fue suspender la importación de estos materiales porque puede ser una de las vías de ingreso del fusarium, o de dispersión del fusarium", destaca Almeida.
Las medidas se actualizan constantemente: al momento, todos los contenedores que ingresan por los puertos ecuatorianos son desinfectados; se desinfecta maquinaria que pueda ser utilizada en construcción, en vialidad u otros; igualmente, vehículos y personas que ingresan por la frontera norte y por frontera sur cumplen un procedimiento estricto de desinfección.

11 de marzo 2021, 21:43 GMT
En los pasos peatonales de frontera están instalados arcos de desinfección; se utilizan bombas estacionarias para desinfectar vehículos, y pediluvios para la desinfección de calzado, con lo que se busca evitar el posible ingreso de esporas del hongo.
En 2020, Ecuador actualizó el Plan de Contingencia para fortalecer las medidas de cuarentena y de bioseguridad de cada finca bananera. Este incluye establecer los puntos críticos de ingreso y capacitar a los productores para que implementen acciones como desinfección del calzado, machetes y otras herramientas de trabajo.

24 de febrero 2021, 15:29 GMT
Desde 2019, Agrocalidad y el Ministerio de Agricultura mantienen campañas de capacitación para los cerca de 15.000 productores bananeros.
Entre 2019 y 2020 se capacitó a cerca de 20.000 actores de la cadena productiva, con especial énfasis en pequeños productores, que constituyen el 80% de cultivadores de la fruta.
"Agrocalidad tiene un equipo especializado de técnicos en campo haciendo vigilancia activa", dice Almeida.
La vigilancia, desde 2018, se hace a través de una modelación de mapas de riesgo para determinar cuáles son los puntos críticos en los que hay que enfocar los esfuerzos para detectar posibles plantas con síntomas y, si las hay, tomar muestras y enviarlas al laboratorio.
14 de agosto 2019, 18:41 GMT
Desde 2018 el equipo ha hecho cerca de 40.000 monitoreos en todas las zonas bananeras del país.
Cuando el hongo llegó a Colombia, en 2019, se incrementaron las inspecciones en frontera, los controles en pasajeros y el contacto con los productores para que se implementen las medidas de bioseguridad.
Entra limpio y sal limpio
Entre los productores se ha impartido el concepto "entra limpio, sal limpio", con el que se exhorta a los trabajadores a la desinfección tanto al ingreso como a la salida de la finca para evitar que se disemine cualquier tipo de problema fitosanitario a otras áreas.

31 de octubre 2017, 03:25 GMT
Agrocalidad también ha conformado el denominado Comando Raza 4, conformado por técnicos que han sido entrenados por entes como el Organismo Internacional Regional de Sanidad Agropecuaria de Centroamérica (OIRSA) para que adopten tanto las medidas preventivas como las emergentes ante una alerta, un supuesto brote o un brote.
Los integrantes del Comando están en toda la zona bananera, pero han redoblado esfuerzos en la zona sur, desde que se confirmó el brote en Perú, más cercano a la zona bananera de Ecuador.